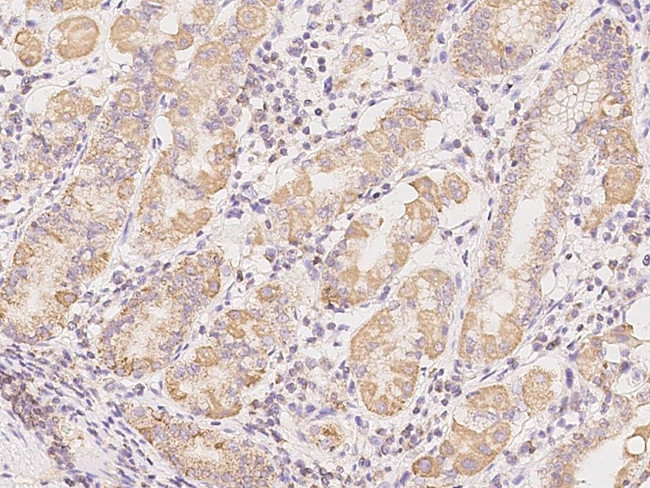
CSK Antibody in Immunohistochemistry (Paraffin) (IHC (P))

Search
Invitrogen
CSK Polyclonal Antibody
{{$productOrderCtrl.translations['antibody.pdp.commerceCard.promotion.promotions']}}
{{$productOrderCtrl.translations['antibody.pdp.commerceCard.promotion.viewpromo']}}
{{$productOrderCtrl.translations['antibody.pdp.commerceCard.promotion.promocode']}}: {{promo.promoCode}} {{promo.promoTitle}} {{promo.promoDescription}}. {{$productOrderCtrl.translations['antibody.pdp.commerceCard.promotion.learnmore']}}
产品信息
PA5-117893
种属反应
宿主/亚型
分类
类型
抗原
偶联物
形式
纯化类型
保存液
内含物
保存条件
运输条件
RRID
靶标信息
CSK is a tyrosine kinase that has been shown to downregulate the activity of SRC oncoprotein through phosphorylation of its carboxy terminus. Since cell transformation by SRC is caused by various mechanisms that interfere with this phosphorylation, the CSK gene might function as an antioncogene. CSK plays an important role in the regulation of cell growth, differentiation, migration, and immune responses. CSK phosphorylates tyrosine residues located in the C-terminal tails of Src-family kinases including LCK, SRC, HCK, FYN, LYN, CSK, and YES1. CSK is expressed ubiquitously as a protein of approximately 50 KDa in cytosol, but a fraction distributes to lipid rafts due to interaction with the lipid raft-associated protein PAG (Csk-binding protein).
仅用于科研。不用于诊断过程。未经明确授权不得转售。
篇参考文献 (0)
生物信息学
蛋白别名: C-Src kinase; c-src tyrosine kinase; CSK; CSK, non-receptor tyrosine kinase; MGC117393; Protein-tyrosine kinase CYL; Tyrosine-protein kinase CSK; unnamed protein product
基因别名: CSK
UniProt ID: (Human) P41240
Entrez Gene ID: (Human) 1445